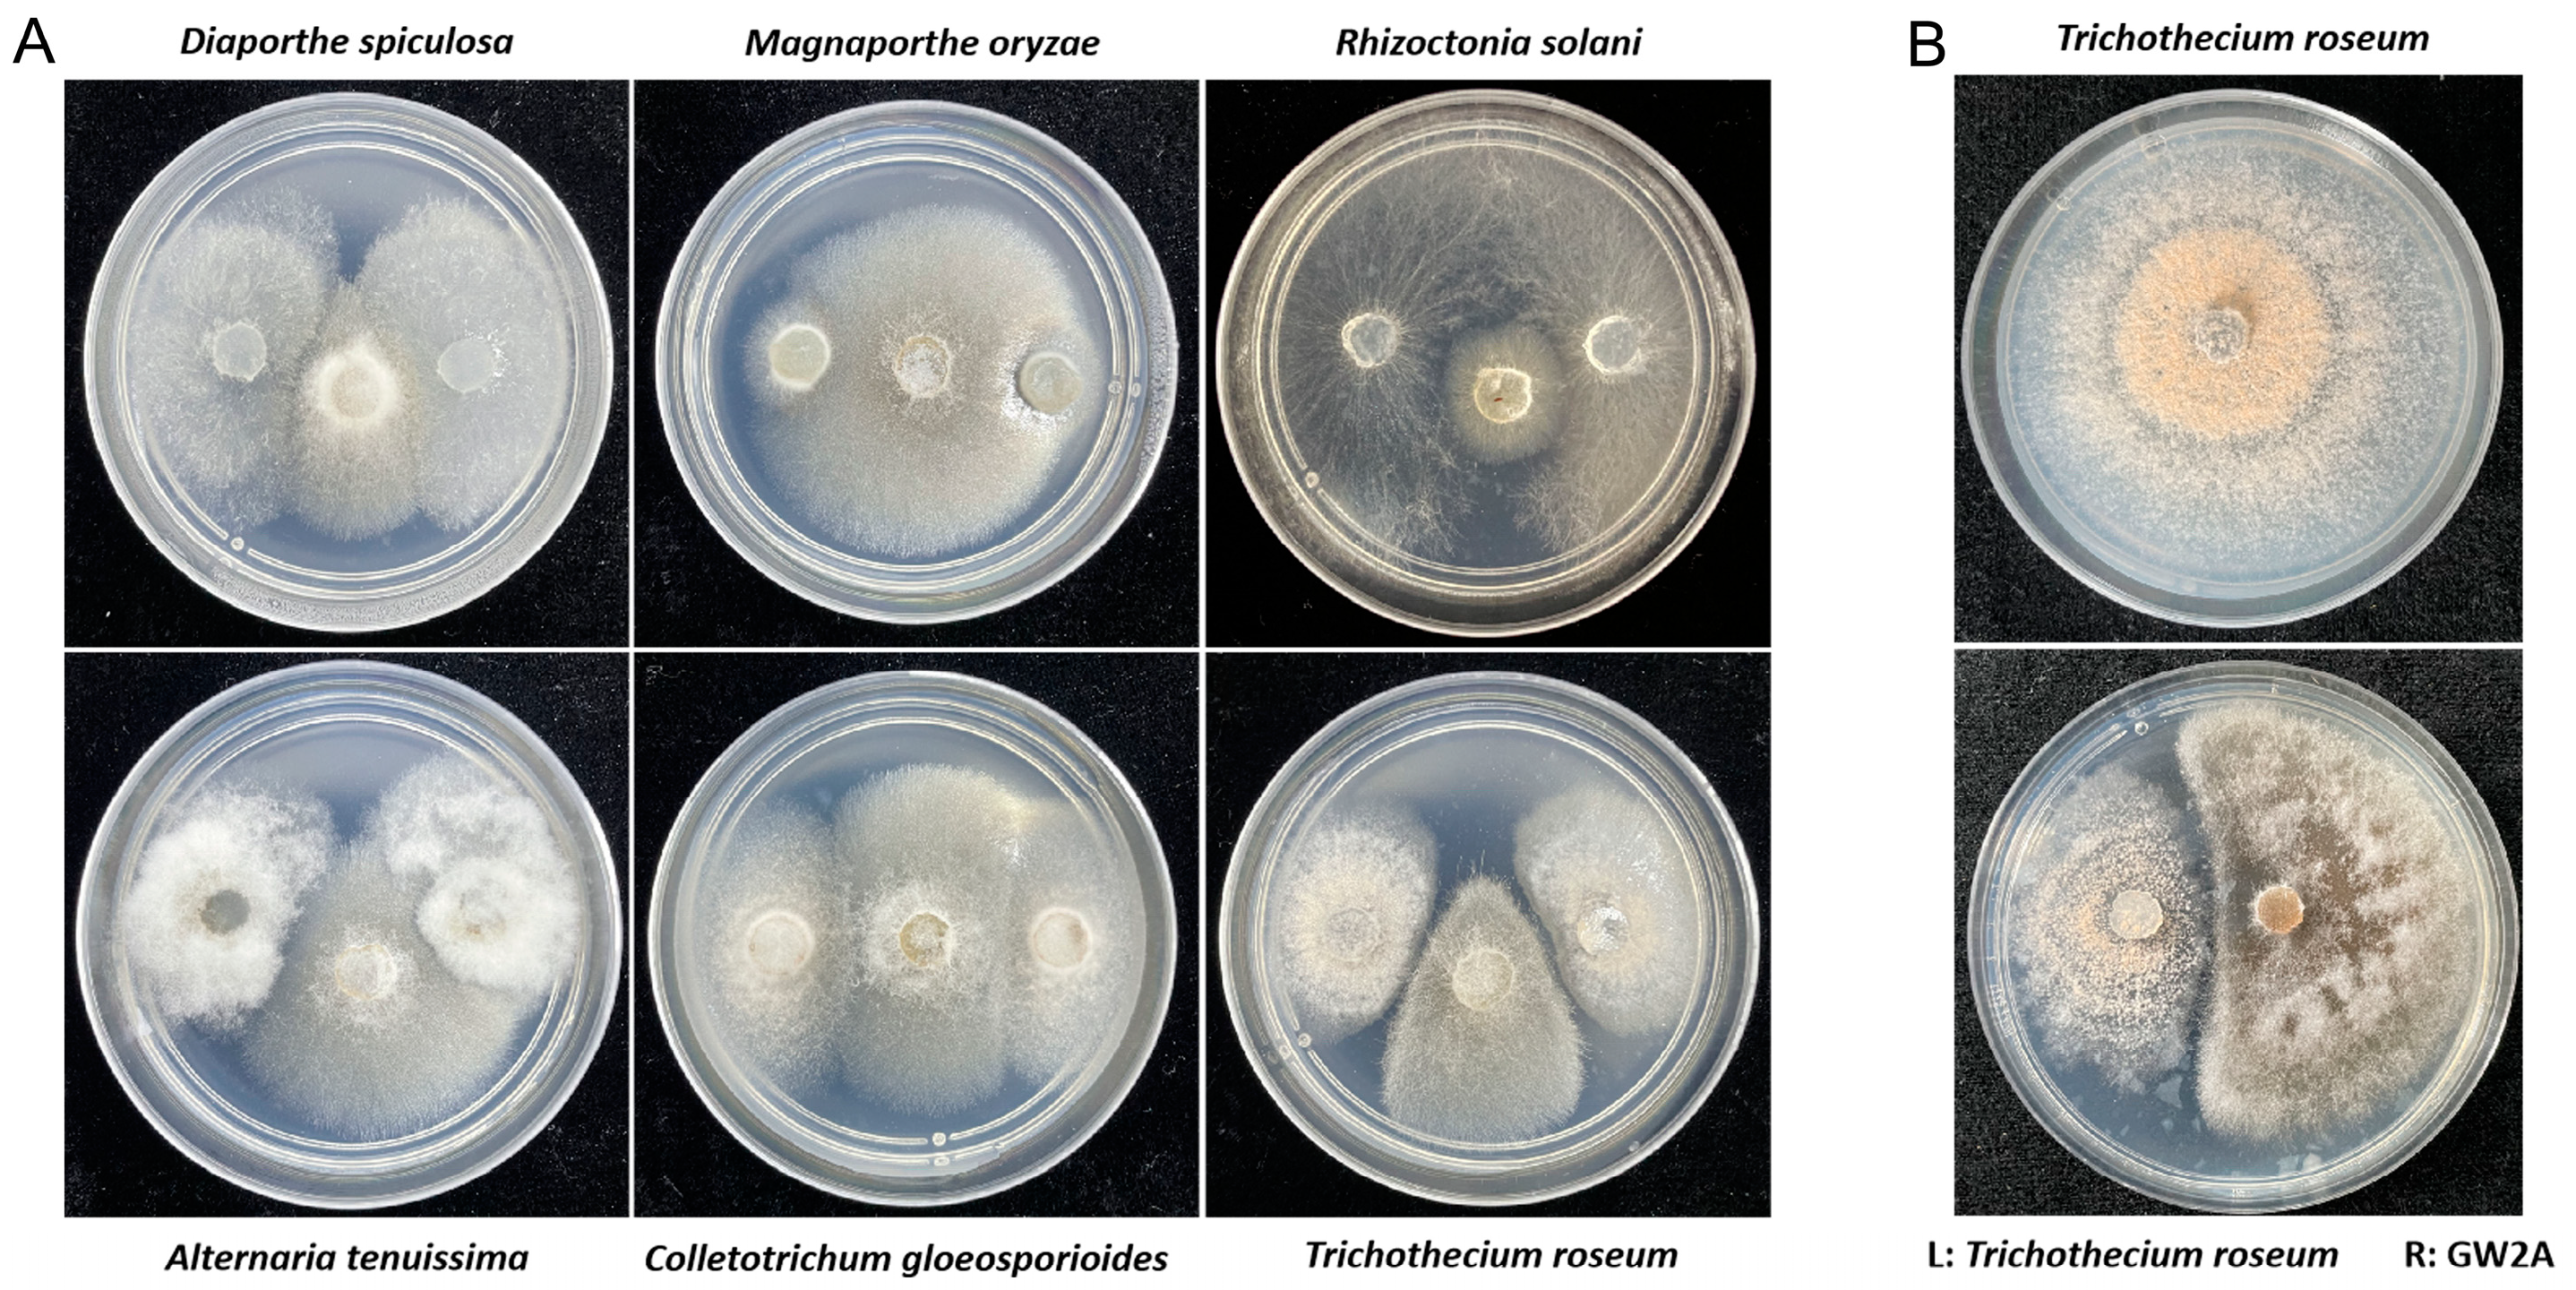
Agronomy 15 00547 g004

Biocontrol Activity of Alternaria angustiovoidea Against Trichothecium roseum Through Inhibiting Its Growth, Pathogenicity, and Gene Expression
Abstract
1. Introduction
2. Materials and Methods
2.1. Fungi and Plant Materials
2.2. Isolation of the GW2A Strain
2.3. Identification of the Fungi Strain
2.4. Determination of the Biological Characteristics of the GW2A Strain
2.4.1. The Effect of Different Carbon Sources on the Growth of the GW2A Strain
2.4.2. The Effect of Different Nitrogen Sources on the Growth of the GW2A Strain
2.4.3. The Effect of Different pHs on the Growth of GW2A
2.4.4. The Effect of Different Temperatures on the Growth of GW2A
2.5. Assessment of Antifungal Activity of GW2A
2.6. The Control Effect of the GW2A Strain on Apple Mold Heart Disease
2.7. Analysis of Defense-Related Gene Expression in Apple Trees
2.8. Transcriptomic Analysis of T. roseum Treated with GW2A
2.9. Transcriptome Data
2.10. Statistical Analyses
2.11. Experiment Date
3. Results
3.1. Isolation and Identification of Sunflower Fungus
3.2. Biological Characteristics of GW2A
3.2.1. Effects of Carbon Sources on Mycelial Growth
3.2.2. Effects of Nitrogen Source on Mycelial Growth
3.2.3. Effects of pH on Mycelial Growth
3.2.4. Effects of Temperature on Fungal Growth
3.3. The GW2A Strain Can Restrict the Growth of T. roseum
3.4. The Prevention Effect of GW2A on T. roseum in Apple Twigs and Fruits
3.5. The Immune-Inducing Effect of GW2A on Apple Twigs
3.6. Transcriptomic Analysis of T. roseum Treated with GW2A
4. Discussion
5. Conclusions
Supplementary Materials
Author Contributions
Funding
Data Availability Statement
Conflicts of Interest
References
- Wang, C.Z.; Wang, X.H.; Jin, Z.N.; Müller, C.; Pugh, T.A.M.; Chen, A.P.; Wang, T.; Huang, L.; Zhang, Y.; Li, L.X.Z.; et al. Occurrence of crop pests and diseases has largely increased in China since 1970. Nat. Food 2022, 3, 57–65. [Google Scholar] [CrossRef] [PubMed]
- Damalas, C.A.; Eleftherohorinos, I.G. Pesticide exposure, safety issues, and risk assessment indicators. Int. J. Environ. Res. Public Health 2011, 8, 1402–1419. [Google Scholar] [CrossRef] [PubMed]
- Aktar, W.; Sengupta, D.; Chowdhury, A. Impact of pesticides use in agriculture: Their benefits and hazards. Interdiscip. Toxicol. 2009, 2, 1–12. [Google Scholar] [CrossRef] [PubMed]
- Elgueta, S.; Moyano, S.; Sepúlveda, P.; Quiroz, C.; Correa, A. Pesticide residues in leafy vegetables and human health risk assessment in North Central agricultural areas of Chile. Food Addit. Contam. 2017, 10, 105–112. [Google Scholar] [CrossRef]
- Tudi, M.; Daniel, R.H.; Wang, L.; Lyu, J.; Sadler, R.; Connell, D.; Chu, C.; Phung, D.T. Agriculture development, pesticide application and its impact on the environment. Int. J. Environ. Res. Public Health 2021, 18, 1112. [Google Scholar] [CrossRef]
- Fang, Y.; Nie, Z.; Die, Q.; Tian, Y.; Liu, F.; He, J.; Huang, Q. Organochlorine pesticides in soil, air, and vegetation at and around a contaminated site in southwestern China: Concentration, transmission, and risk evaluation. Chemosphere 2017, 178, 340–349. [Google Scholar] [CrossRef]
- Mingo, V.; Lötters, S.; Wagner, N. The impact of land use intensity and associated pesticide applications on fitness and enzymatic activity in reptiles—A field study. Sci. Total Environ. 2017, 590, 114–124. [Google Scholar] [CrossRef]
- Singh, D.K. Pesticides and Environment. Pestic. Chem. Toxicol. 2012, 114–122. [Google Scholar]
- He, D.C.; He, M.H.; Amalin, D.M.; Liu, W.; Alvindia, D.G.; Zhan, J. Biological control of plant diseases: An evolutionary and eco-economic consideration. Pathogens 2021, 10, 1311. [Google Scholar] [CrossRef]
- Van, L.J.C.; Bolckmans, K.; Köhl, J.; Willem, J.; Ravensberg, W.J.; Urbaneja, A. Biological control using invertebrates and microorganisms: Plenty of new opportunities. BioControl. 2017, 63, 39–59. [Google Scholar]
- Ab Rahman, S.F.S.; Singh, E.; Pieterse, C.M.; Schenk, P.M. Emerging microbial biocontrol strategies for plant pathogens. Plant. Sci. 2018, 267, 102–111. [Google Scholar] [CrossRef] [PubMed]
- Guo, R.; Wang, Z.; Zhou, C.; Liu, Z.; Zhang, P.; Fan, H. Transcriptomic analysis reveals biocontrol mechanisms of Trichoderma harzianum ACCC30371 under eight culture conditions. J. For. Res. 2020, 31, 393–403. [Google Scholar] [CrossRef]
- Wang, Y.; Wang, J.; Zhu, X.; Wang, W. Genome and transcriptome sequencing of Trichoderma harzianum T4, an important biocontrol fungus of Rhizoctonia solani, reveals genes related to mycoparasitism. Can. J. Microbiol. 2024, 70, 86–101. [Google Scholar] [CrossRef] [PubMed]
- Bae, S.J.; Mohanta, T.K.; Chung, J.Y. Trichoderma metabolites as biological control agents against Phytophthora pathogens. Biol. Control. 2016, 92, 128–138. [Google Scholar] [CrossRef]
- Pakora, G.A.; Mpika, J.; Kone, D.; Ducamp, M.; Kebe, I.; Nay, B.; Buisson, D. Inhibition of Phytophthora species, agents of cocoa black pod disease, by secondary metabolites of Trichoderma species. Environ. Sci. Pollut. Res. Int. 2018, 25, 29901–29909. [Google Scholar] [CrossRef]
- Atanasova, A.; Le Crom, S.; Gruber, S.; Coulpier, F.; Seidl-Seiboth, V.; Kubicek, C.P.; Druzhinina, I.S. Comparative transcriptomics reveals different strategies of Trichoderma mycoparasitism. BMC Genom. 2013, 14, 121. [Google Scholar] [CrossRef]
- Bélanger, R.R.; Labbé, C.; Lefebvre, F.; Teichmann, B. Mode of action of biocontrol agents: All that glitters is not gold. Can. J. Plant Pathol. 2012, 34, 469–478. [Google Scholar] [CrossRef]
- Raio, A.; Puopolo, G. Pseudomonas chlororaphis metabolites as biocontrol promoters of plant health and improved crop yield. World J. Microbiol Biotechnol. 2021, 37, 99. [Google Scholar] [CrossRef]
- Xin, Y.F.; Shang, J.J. Bio-control trials of Chaetomium spirale ND35 against apple canker. J. For. Res. 2005, 16, 121–124. [Google Scholar]
- Bolton, M.D.; Thomma, B.P.; Nelson, B.D. Sclerotinia sclerotiorum (Lib.) de bary: Biology and molecular traits of a cosmopolitan pathogen. Mol. Plant. Pathol. 2006, 7, 1–16. [Google Scholar] [CrossRef]
- Ding, L.N.; Li, T.; Guo, X.J.; Li, M.; Liu, X.Y.; Cao, J.; Tan, X.L. Sclerotinia stem rot resistance in rapeseed: Recent progress and future prospects. J. Agric. Food. Chem. 2021, 69, 2965–2978. [Google Scholar] [CrossRef] [PubMed]
- Liang, X.; Rollins, J.A. Mechanisms of broad host range necrotrophic pathogenesis in Sclerotinia sclerotiorum. Phytopathology 2018, 108, 1128–1140. [Google Scholar] [CrossRef] [PubMed]
- Zheng, L.; Zhao, J.; Liang, X.; Zhan, G.; Jiang, S.; Kang, Z. Identification of a novel Alternaria alternata strain able to hyperparasitize Puccinia striiformis f. sp. tritici, the causal agent of wheat stripe rust. Front. Microbiol. 2017, 8, 71. [Google Scholar] [CrossRef] [PubMed]
- Qian, Z.; Tong, L.H.; Shu, T.W. Biocontrol efficacy of endophytic Alternaria Al67 from apple bark against apple tree Valsa canker. J. Agric. Univ. Hebei 2014. [Google Scholar] [CrossRef]
- National Bureau of Statistics. 2024. Available online: https://www.stats.gov.cn/ (accessed on 30 December 2024).
- Dai, P.; Jiang, Y.; Liang, X.; Gleason, M.L.; Zhang, R.; Sun, G. Trichothecium roseum enters ‘Fuji’ apple cores through stylar fissures. Plant Dis. 2020, 104, 1060–1068. [Google Scholar] [CrossRef]
- Hamid, M.I.; Hussain MGhazanfar, M.U.; Raza, M.; Liu, X.Z. Trichothecium roseum causes fruit rot of tomato, orange, and apple in pakistan. Plant Dis. 2014, 98, 1271. [Google Scholar] [CrossRef]
- Serdani, M.; Crous, P.W.; Holz, G.; Petrini, O. Endophytic fungi associated with core rot of apples in south Africa, with specific reference to Alternaria species. Sydowia 1998, 50, 257–271. [Google Scholar]
- Spotts, R.A. Moldy core and core rot. In Compendium of Apple and Pear Diseases; Jones, A.L., Aldwinckle, H.S., Eds.; American Phytopathology Society: Saint Paul, MN, USA, 1990; pp. 29–30. [Google Scholar]
- Niu, L.L.; Bi, Y.; Bai, X.D.; Zhang, S.G.; Xue, H.L.; Li, Y.C.; Wang, Y.; Calderón-Urrea, A. Damage to Trichothecium roseum caused by sodium silicate is independent from pH. Can. J. Microbiol. 2016, 62, 161–172. [Google Scholar] [CrossRef]
- Tang, Y.; Xue, H.; Bi, Y.; Li, Y.; Wang, Y.; Zhao, Y.; Shen, K. A method of analysis for T-2 toxin and neosolaniol by UPLC-MS/MS in apple fruit inoculated with Trichothecium roseum. Food Addit. Contam. Part A 2015, 32, 480–487. [Google Scholar] [CrossRef]
- Lv, X.; Ma, H.; Lin, Y.; Bai, F.; Ge, Y.; Zhang, D.; Li, J. Antifungal activity of Lactobacillus plantarum C10 against Trichothecium roseum and its application in promotion of defense responses in muskmelon (Cucumis melo L.) fruit. J. Food Sci. Technol. 2018, 55, 3703–3711. [Google Scholar] [CrossRef]
- Zhao, L.; Wang, J.; Zhang, H.; Peng, Q.; Fan, C.; Zhou, Y.; Zhang, X. Cell structure damage contributes to antifungal activity of sodium propylparaben against Trichothecium roseum. Pestic. Biochem. Physiol. 2024, 198, 105758. [Google Scholar] [CrossRef] [PubMed]
- Yan, H.; Yun, J.; Ai, D.; Zhang, W.; Bai, J.; Guo, J. Two novel cationic antifungal peptides isolated from Bacillus pumilus HN-10 and their inhibitory activity against Trichothecium roseum. World J. Microbiol. Biotechnol. 2018, 34, 21. [Google Scholar] [CrossRef] [PubMed]
- Pilkington, L.J.; Messelink, G.; van Lenteren, J.C.; Le, M.K. Protected biological control—Biological pest management in the greenhouse industry. Biol. Control. 2010, 52, 216–220. [Google Scholar] [CrossRef]
- Bale, J.S.; van Lenteren, J.C.; Bigler, F. Biological control and sustainable food production. Philos. Trans. R. Soc. B Biol. Sci. 2008, 363, 761–776. [Google Scholar] [CrossRef]
- He, Y.; Tian, R.; Gao, C.; Ji, L.; Liu, X.; Feng, H.; Huang, L. Biocontrol activity of an endophytic Alternaria alternata Aa-Lcht against apple Valsa canker. Pestic. Biochem. Physiol. 2024, 200, 105813. [Google Scholar] [CrossRef]
- Chen, S.; Zhou, Y.; Chen, Y.; Gu, J. fastp: An ultra-fast all-in-one FASTQ preprocessor. Bioinformatics 2018, 34, 884–890. [Google Scholar] [CrossRef]
- Kim, D.; Langmead, B.; Salzberg, S.L. HISAT: A fast spliced aligner with low memory requirements. Nat. Methods 2015, 12, 357–360. [Google Scholar] [CrossRef]
- Anders, S.; Pyl, P.T.; Huber, W. HTSeq—A Python framework to work with high-throughput sequencing data. Bioinformatics 2015, 31, 166–169. [Google Scholar] [CrossRef]
- Love, M.I.; Huber, W.; Anders, S. Moderated estimation of fold change and dispersion for RNA-seq data with DESeq2. Genome Biol. 2014, 15, 550. [Google Scholar] [CrossRef]
- The Gene Ontology Consortium. The Gene Ontology Resource: 20 years and still GOing strong. Nucleic Acids Res. 2019, 47, 330–338. [Google Scholar] [CrossRef]
- Kanehisa, M.; Araki, M.; Goto, S.; Hattori, M.; Hirakawa, M.; Itoh, M.; Katayama, T.; Kawashima, S.; Okuda, S.; Tokimatsu, T.; et al. KEGG for linking genomes to life and the environment. Nucleic Acids Res. 2008, 36, 480–484. [Google Scholar] [CrossRef] [PubMed]
- Barnett, H.L.; Hunter, B.B. Illustrated Genera of Imperfect Fungi; APS Press: St. Paul, MN, USA, 1998; p. 122. [Google Scholar]
- Simmons, E.G. Alternaria: An Identification Manual; CBS: Utrecht, The Netherlands, 2007. [Google Scholar]
- White, T.J. A Guide to Methods and Applications; Academic Press: San Diego, CA, USA, 1990. [Google Scholar]
- Berbee, M.L. Cochliobolus phylogenetics and the origin of known, highly virulent pathogens, inferred from ITS and glyceraldehyde-3-phosphate dehydrogenase gene sequences. Mycologia 1999, 91, 964. [Google Scholar] [CrossRef]
- Li, Y.; Yang, Z.; Wang, W.; Wang, X.; Zhang, C.; Dong, J.; Bai, M.; Hui, T. Research progress of rapid non-destructive detection technology in the field of apple mold heart disease. Molecules 2023, 28, 7966. [Google Scholar] [CrossRef]
- Guo, S.P. Apple mold heart disease. In New Color Atlas of Fruit Tree Disease And pest Control; China Agricultural Science and Technology Press: Beijing, China, 2010; pp. 12–13. ISBN 978-7-81117-973-6. [Google Scholar]
- Zhang, X.F. Prevention and control techniques of apple mold heart disease. Hebei Fruits 2017, 3, 19–20. [Google Scholar]
- Lawrence, D.P.; Gannibal, P.B.; Peever, T.L. The sections of Alternaria: Formalizing species-group concepts. Mycologia 2013, 105, 530–546. [Google Scholar] [CrossRef] [PubMed]
- Simmons, E.G. Alternaria taxonomy: Current status, viewpoint, challenge. In Alternaria Biology, Plant Diseases and Metabolites; Chelkowski, J., Visconti, A., Eds.; Elsevier Science Publishers: Amsterdam, The Netherlands, 1992; pp. 1–35. [Google Scholar]
- Fanele, A.; Ndlovu, S.I. Endophytic fungal species Nigrospora oryzae and Alternaria alternata exhibit antimicrobial activity against gram-positive and gram-negative multi-drug resistant clinical bacterial isolates. BMC. Complement. Med. Ther. 2023, 23, 323. [Google Scholar] [CrossRef]
- Ghosh, R.J.; Barman, S.; Jgs, P.K.; Mandal, N.C. Biological activities of Alternaria sp. RL4 a potent endophytic fungus associated with Rauvolfia serpentina L. benth. Asian J. Pharm. Clin. Res. 2019, 11, 178. [Google Scholar] [CrossRef]
- Xu, R.; Song, S.; Wu, G. Biocontrol ability of Arcopilus aureus YZXR against Fusarium fujikuroi causing leaf spot on Polygonatum odoratum. Phytopathol. Res. 2024, 6. [Google Scholar] [CrossRef]
- Nandakumar, R.; Babu, S.; Viswanathan, R. Induction of systemic resistance in rice against sheath blight disease by Pseudomonas fluorescens. Soil Biol. Biochem. 2001, 33, 603–612. [Google Scholar] [CrossRef]
- Zimmerli, L.; Jakab, G.; Metraux, J.P.; Mauch-Mani, B. Potentiation of pathogen-specific defense mechanisms in Arabidopsis by beta-aminobutyric acid. Proc. Natl. Acad. Sci. USA 2000, 97, 12920–12925. [Google Scholar] [CrossRef]
- Lamb, C.; Dixon, R.A. The wxidative burst in plant disease resistance. Annu. Rev. Plant Physiol. Plant Mol. Biol. 1997, 48, 251–275. [Google Scholar] [CrossRef]
- Shoresh, M.; Yedidia, I.; Chet, I. Involvement of jasmonic acid/ ethylene signaling pathway in the systemic resistance induced in cucumber by Trichoderma asperellum T203. Phytopathology 2005, 95, 76–84. [Google Scholar] [CrossRef] [PubMed]
- Richards, T.A.; Talbot, N.J. Horizontal gene transfer in osmotrophs: Playing with public goods. Nat. Rev. Microbiol. 2013, 11, 720–727. [Google Scholar] [CrossRef] [PubMed]
- Harman, G.E.; Howell, C.R.; Viterbo, A.; Chet, I.; Lorito, M. Trichoderma species—Opportunistic, avirulent plant symbionts. Nat. Rev. Microbiol. 2004, 2, 43–56. [Google Scholar] [CrossRef] [PubMed]
- Lacey, L.A.; Grzywacz, D.; Shapiro-Ilan, D.I.; Frutos, R.; Brownbridge, M.; Goettel, M.S. Insect pathogens as biological control agents: Back to the future. J. Invertebr. Pathol. 2015, 132, 1–41. [Google Scholar] [CrossRef]
- Vinale, F.; Sivasithamparam, K.; Ghisalberti, E.L.; Marra, R.; Woo, S.L.; Lorito, M. Trichoderma–plant–pathogen interactions. Soil Biol. Biochem. 2008, 40, 1–10. [Google Scholar] [CrossRef]
- Shoresh, M.; Harman, G.E.; Mastouri, F. Induced systemic resistance and plant responses to fungal biocontrol agents. Annu. Rev. Phytopathol. 2010, 48, 21–43. [Google Scholar] [CrossRef]

Disclaimer/Publisher’s Note: The statements, opinions and data contained in all publications are solely those of the individual author(s) and contributor(s) and not of MDPI and/or the editor(s). MDPI and/or the editor(s) disclaim responsibility for any injury to people or property resulting from any ideas, methods, instructions or products referred to in the content. |
© 2025 by the authors. Licensee MDPI, Basel, Switzerland. This article is an open access article distributed under the terms and conditions of the Creative Commons Attribution (CC BY) license (https://creativecommons.org/licenses/by/4.0/).
Share and Cite
Guo, X.; Xu, M.; Wang, S.; Zhang, W.; Liu, B. Biocontrol Activity of Alternaria angustiovoidea Against Trichothecium roseum Through Inhibiting Its Growth, Pathogenicity, and Gene Expression. Agronomy 2025, 15, 547. https://doi.org/10.3390/agronomy15030547
Guo X, Xu M, Wang S, Zhang W, Liu B. Biocontrol Activity of Alternaria angustiovoidea Against Trichothecium roseum Through Inhibiting Its Growth, Pathogenicity, and Gene Expression. Agronomy. 2025; 15(3):547. https://doi.org/10.3390/agronomy15030547
Chicago/Turabian StyleGuo, Xiuna, Meiting Xu, Shaoli Wang, Wei Zhang, and Baoyou Liu. 2025. "Biocontrol Activity of Alternaria angustiovoidea Against Trichothecium roseum Through Inhibiting Its Growth, Pathogenicity, and Gene Expression" Agronomy 15, no. 3: 547. https://doi.org/10.3390/agronomy15030547
APA StyleGuo, X., Xu, M., Wang, S., Zhang, W., & Liu, B. (2025). Biocontrol Activity of Alternaria angustiovoidea Against Trichothecium roseum Through Inhibiting Its Growth, Pathogenicity, and Gene Expression. Agronomy, 15(3), 547. https://doi.org/10.3390/agronomy15030547

